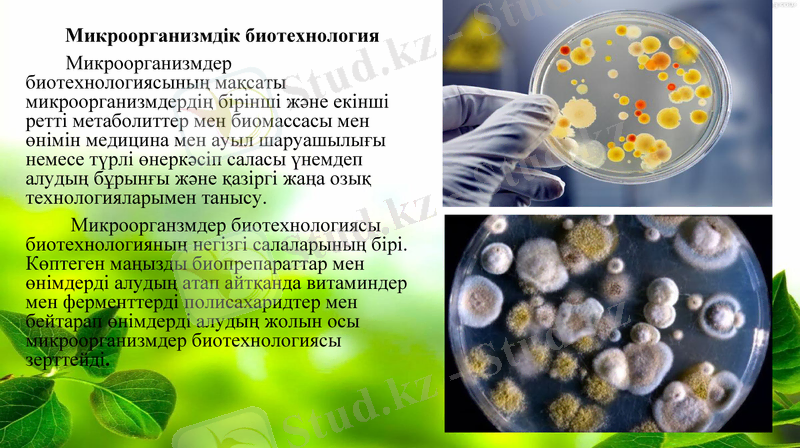
Slide 5

Микроорганизмдік биотехнологияның негіздері: ашу процесі, этанол мен сүт қышқылы өндірісі



Қазақ Ұлттық университеті Технология және биоресурстар факультеті
Тақырыбы:Микроорганизімдер
биотехнологиясы.
Орындаған: Аязбай Л. Б
Тексерген:Байхожаева Б. Ә

Мазмұны
I. Кіріспе
II. Негізгі бөлім
1. Биотехнология.
2. Биотехнология салалары.
3. Микроорганизмдік биотехнологи
4. Ашу өндірісі.
5. Спирттік ашу процесі. Этанолды алу
6. Сүт қышқылын алу.
III. Қорытынды
IV. Пайдаланылған әдебиеттер

Биотехнология
Биотехнология (bios - тіршілік; thechne-өнер, шеберлік; logos-ғылым) - адамның қатысуымен тірі ағзаларда биологиялық процестерді жүргізу барысында жаңа өнім алу; экономикалық құнды заттарды алу үшін ген және жасуша деңгейінде өзгертілген биологиялық объектілерді құрастыру технологиялары мен пайдалану жөніндегі ғылым және өндіріс саласы.
Биотехнологияның негізгі объектісі - тірі жасушалар, атап айтқанда жануар, өсімдік текті жасушалар және микробтар немесе олардың биологиялық белсенді метаболиттері.
Алғаш рет «биотехнология» термині 1917 жылы Карл Эреки шошқаларды қант қызылшасымен қоректендіру кезінде олардың өнімдерінің жоғарылауы жасалған жұмыстарының нәтижесінде берілген.
Биотхнология-биологиялық процестердің өту заңдылықтарын терең зеттеп, ұғу арқасында биологиялық объектілердің қызметін пайдалану негізінде іске асырылатын қазіргі заманның өте тиімді де биік деңгейдегі технологиясы

Биотехнология салалары
Өсімдік биотехнологиясы.
Медициналық биотехноогиясы.
Экологиялық биотехнология.
Өндірістік биотехнология.
Иммундық биотехнология.
Микроорганизмдік биотехнология.
Микроорганизмдік биотехнология
Микроорганизмдер биотехнологиясының мақсаты микроорганизмдердің бірінші және екінші ретті метаболиттер мен биомассасы мен өнімін медицина мен ауыл шаруашылығы немесе түрлі өнеркәсіп саласы үнемдеп алудың бұрынғы және қазіргі жаңа озық технологияларымен танысу.
Микроорганзмдер биотехнологиясы биотехнологияның негізгі салаларының бірі. Көптеген маңызды биопрепараттар мен өнімдерді алудың атап айтқанда витаминдер мен ферменттерді полисахаридтер мен бейтарап өнімдерді алудың жолын осы микроорганизмдер биотехнологиясы зерттейді.

Ашу өндірісі.
Ашу - субстраттың толық тотығуы жүрмейтін және АТФ түзілуімен сипатталатын метаболиттік процесс. Көмірсутегілер мен бірқатар басқа да заттардың ашуы кезінде, мынандай өнімдер түзілуі мүмкін: этанол, лактат, пропионат, формиат, бутират, сукцинат, капронат. ацетат, н-бутанол, 2, 3-бутандиол, ацетон, 2-пропанол, көмірқышқыл газы және молекулалық сутегі. Түзілген өнімнің түріне байланысты ашу процесінің бірнеше түрін ажыратады:
1. Спирттік ашу процесі;
2. Сүт қышқылдық ашу процесі;
3. Пропион қышқылдық ашу процесі;
4. Құмырсқа қышқылдық ашу процесі;
5. Май қышқылдық ашу процесі;
6. Сірке қышқылдық ашу процесі.

Спирттік ашу процесі. Этанолды алу
Спирттік ашу процесін әр түрлі микроорганизмдер жүргізеді. Көмірсутегілерден тұратын шикізаттан ферментациялық жолмен этанолды алу үшін көбінесе Saccharomyces туысына жататын ашытқыларды пайдаланады, ал Шығыс елінде спирттік сусын саке дайындау үшін -Aspergillus oryzae саңырауқұлағын, ал Мексикада алкагольдік өнім пулькені Zymomonas mobilis бактериясы көмегімен дайындайды, сүт сарысуындағы лактозаны ашыту үшін сүт ашытқысы деп аталатын ұйытқыны алу үшін Kluyveromyces fragilis, Kluyveromyces lactis және т. б. кеңінен қолданады.
Спирттік сусындар өндірісінде рафинозаны ашыту қабілеттілігімен ерекшеленетін Saccharomyces carlsbergenses және Saccharomyces cerevisiae
ашытқы штамдары қолданылады.

Спирт өндірісінде қолданылатын ашытқыларды төменгі деңгейдегі ашу процесінің рассалары және жоғары деңгейдегі рассалар деп екіге бөледі.
Төменгі деңгейдегі ашу рассалары 6-100 С және одан да төмен температурада қызмет етеді, ал процесс соңында ыдыс түбіне шөгіп, қалың тығыз тұнба түзеді. Оларға көбінесе шараптық және сыра сахаромицеттері жатады.
Жоғары деңгейдегі ашу рассалары 14-25°С температурада жұмыс жасайды, ал процесс соңында шараптың бетіне көтеріліп, қалпақ тәрізді қабық түзейді. Бұл қабық ашытқы клеткаларының бүршіктенуден кейін топтасқан күйінде қалып, көмірқышқыл газының көпіршіктерімен бірге жоғары көтеріледі. Жоғары деңгейдегі ашу рассаларына спирт, нан және сыра өндірісінің ашытқылары жатады.

Спирттік ашытқыларды мерзімді дақылдау кезінде бастапқы концентрациясында 20-25% қанттан 10-13% этанол түзіледі. Ферментация уақыты 48-72 сағат. Бұл әдіс 25, 5 кг бидайдан 8, 7-9, 8 л спирт және 7, 7 кг құрғақ зат қалдықтарын алуға мүмкіндік береді.
Целлюлозалы өсімдік шикізаттары қысым әсерімен қышқылдық гидролизге ұшырайды. Алынған гидролизат шамамен 3, 2-3, 5% редуцияланатын қанттардан яғни глюкоза, галактоза, маннноза және ментозалардан тұрады.
Соңғы кезде зерттеушілердің назарын спирт өндірісінде, субстрат ретінде екіншілік шикізаттарды қолдану мәселелері қызықтыруда. Мәселен, сүтті және майсызданған сүтті ірімшік, сүзбе, казеин және әр түрлі сүт-белоктық концентраттарды өңдеуде түзілген екіншілік шикізат - сүт сарысуын пайдалануға көп көңіл бөлінуде. Сүт сарысуы сүттің 50-75% құрғақ заты мен сүт қанты-лактозаның 4, 5% мөлшерінен тұратын биологиялық бағалы және құндылығы жоғары шикізат болып табылады. Жыл сайын әлемдегі сүт өнімдерін өңдеуден 74 млн тонна сүт сарысуы алынады, оның ішіндегі 16 млн тонна АҚШ, шамамен 25 млн тонна ЕЭО елдерінде, ал ТМД елдерінде шамамен 15 млн тонна өндіріледі.

Сүт сарысуы өте құнды бай қоректік орта болып табылады, сондықтан ол әр түрлі химиялық қосылыстарды түзетін микроорганизмдердің өсуі үшін толық құнды субстрат бола алады. Сүт сарысуы негізінде этанол өндірудің тиімділігі жоғары екендігі көрсетілген. Мысалы, АҚШ-та 1 жыл ішінде этанолды 1, 6 млн тоннаға дейін өндіретін, ал 1 тәулікте 225 тоннаға дейін сүт сарысуын өңдейтін қондырғылар жұмыс істейді. Қазіргі кезде Жаңа Зеландия мен Бразилия елдерінде двигательдегі бензині 20-50% сүт сарысуынан алынған этанолға ауыстырылған. Сонымен бірге, сүт сарысуынан этанолдан басқа белоктар және спирттен кейінгі ашыған заттар сияқты аралық өнімдер түзіледі. Оларды кептіріп, ауыл шаруашылықта мал азығы ретінде пайдалануға болады. Этанолды сүт сарысуынан өндіру, картоп немесе бидай шикізатынан өндірумен салыстырғанда экономикалық тиімділігі жоғары.

Сүт қышқылын алу
1847 жылы С. Блондо алғаш рет сүт қышқылы - ашу процесінің өнімі екенін көрсетті, ал Луи Пастер бұл ашуды бактериялар туғызатынын дәлелдеді. Сүт қышқылын микробиологиялық синтез жолымен өндіру 1881 жылдан бері белгілі. Сүт қышқылы тамақ өнеркәсібінде, медицинада шикізат ретінде химиялық синтезде, тері және т. б. өндірістерде кеңінен қолданылады.
Көмірсулардың сүт қышқылына дейін ашуы сүтқышқылды бактериялардың көмегімен жүзеге асады. Гомоферментативті ашудың негізгі өнімі - сүт қышқылы, ал гетероферментативті ашудың өнімі сүт қышқылымен қатар сірке қышқылы, этанол және көмір қышқыл газы болып табылады.
Ашу процесін біраз қышқылдандырьшған ортада 2-7 тәулік аралығыңда, 49-50°С температурада мерзімді дақылдау жағдайда жүргізеді, ал сүт қышқылын бөліп алу мен тазалау бірқатар қиыншылықтар туғызады. Сүт қышқылы нашар кристалданады және таза күйінде суды тез сіңіретін түссіз сироп түрінде болады (бұл көбінесе 65%-дық ерітінді күйінде кездеседі) .
- Іс жүргізу
- Автоматтандыру, Техника
- Алғашқы әскери дайындық
- Астрономия
- Ауыл шаруашылығы
- Банк ісі
- Бизнесті бағалау
- Биология
- Бухгалтерлік іс
- Валеология
- Ветеринария
- География
- Геология, Геофизика, Геодезия
- Дін
- Ет, сүт, шарап өнімдері
- Жалпы тарих
- Жер кадастрі, Жылжымайтын мүлік
- Журналистика
- Информатика
- Кеден ісі
- Маркетинг
- Математика, Геометрия
- Медицина
- Мемлекеттік басқару
- Менеджмент
- Мұнай, Газ
- Мұрағат ісі
- Мәдениеттану
- ОБЖ (Основы безопасности жизнедеятельности)
- Педагогика
- Полиграфия
- Психология
- Салық
- Саясаттану
- Сақтандыру
- Сертификаттау, стандарттау
- Социология, Демография
- Спорт
- Статистика
- Тілтану, Филология
- Тарихи тұлғалар
- Тау-кен ісі
- Транспорт
- Туризм
- Физика
- Философия
- Халықаралық қатынастар
- Химия
- Экология, Қоршаған ортаны қорғау
- Экономика
- Экономикалық география
- Электротехника
- Қазақстан тарихы
- Қаржы
- Құрылыс
- Құқық, Криминалистика
- Әдебиет
- Өнер, музыка
- Өнеркәсіп, Өндіріс
Қазақ тілінде жазылған рефераттар, курстық жұмыстар, дипломдық жұмыстар бойынша біздің қор #1 болып табылады.



Ақпарат
Қосымша
Email: info@stud.kz